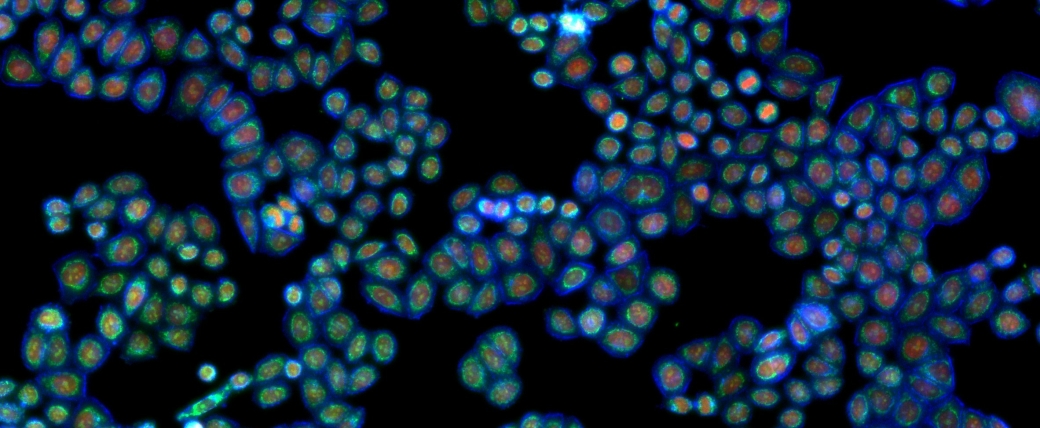
Many small oval cells in clusters against a black background, with blue perimeters and red and green inside

Annual Report 2025

When our Founding Director, David Baltimore, passed away in September, he left a profound legacy. Alongside Jack Whitehead, David established Whitehead Institute as an independent hub with the singular vision of accelerating biomedical discovery and advancing human health. Together, they recruited both established scientists and younger, unproven ones, like me, to work in a research ecosystem that fostered collaboration. They invited us to tackle biology’s toughest questions. David’s impact was felt not just by us, but also by the broader scientific community, as he shaped institutions, nurtured countless careers, and was an ardent advocate for science.
As the nation’s scientific enterprise faces unprecedented challenges, Whitehead Institute is more committed than ever to accelerating discovery and innovation by supporting our scientists. This Report offers a look at our science, training, and outreach, revealing how our work — with your help — narrows the gap between discoveries and better health for all. Your support fuels the bold ideas and groundbreaking biomedical research that will bring tomorrow’s cures and forge real solutions to the defining challenges of our time, from human disease to the climate crisis.
Whitehead scientists embrace the power of curiosity, asking daring questions and developing innovative strategies. This year, they explored how proteins move through cells, how the same genetic code can produce different proteins, how a cancer cell grows into a tumor, how sperm production can influence offspring sex, and how certain cells can resist aging. Each discovery advances understanding — of rare diseases, cancer, diabetes, and other chronic diseases — and may move boundaries for prevention and treatment.
Through the Whitehead Innovation Initiative (WII), Whitehead Institute is fostering a new era of discovery by leveraging AI and other emerging technologies to accelerate progress in biology. In its inaugural year, WII-supported projects showed remarkable progress, culminating in the standing-room-only symposium AI: Advancing Foundational Biology.
Whitehead community spirit remains strong. The Whitehead Institute nurtures future scientific and thought leaders through its commitments to fellows, junior faculty, and trainees, as well as through educational programs for middle and high school students and their teachers. Our newly launched alumni network is strengthening connections beyond Kendall Square. As our alumni forge new paths, we are so proud of their accomplishments. A highlight for reflection this year was the retirement symposium celebrating Founding Member and former Director Gerald Fink and his new book, The Creation of Whitehead Institute: A Radical Experiment.
We are also excited to welcome Ron Vale, a pioneering cell biologist and HHMI Investigator, who will be joining Whitehead Institute and the MIT faculty. Formerly at UCSF and the HHMI Janelia Research Campus, Ron will promote global education through MIT Open Learning, integrating biology and artificial intelligence. We look forward to his inspiring contributions in research and teaching.
Advancing science and empowering the next generation are not only central to Whitehead Institute’s mission, but are also key to meeting today’s challenges. By emboldening young scientists to tackle the toughest questions with confidence and creativity, we carry forward David Baltimore’s legacy and lay the groundwork that will inspire and sustain the future. I am thrilled to share some of this year’s accomplishments with you and to look ahead to what we can achieve together.

Whitehead Institute researchers investigate biological processes to uncover the mechanisms that drive everything from embryonic development and aging to neurodegenerative disorders, rare diseases, cancer, diabetes, viral infections, and more. By creating novel research tools and generating transformative insights, they lay the groundwork for future therapies and interventions that can improve human health. Explore selected research highlights and news stories from across Whitehead Institute over the past year.
Investigating rare genomic integration of coronavirus into the human genome. Read more.
Investigating proteins that give parasites their changing form and function. Read more.
Developing biological nanoparticles as vehicles for large-molecule therapies. Read more.

These news features explore key initiatives and partnerships at Whitehead Institute. Learn why our physician-scientists view Whitehead as the best place to advance discoveries that improve patient care. Delve into the Whitehead Innovation Initiative and the growing impact of AI on biomedicine. And discover how our Innovation Centers function not just as research hubs, but as active thought partners that help shape the next generation of scientific leaders.
Whitehead Institute’s physician-scientists — researchers who also practice medicine — are highly motivated by the goal of improving patients’ outcomes. What drew them to Whitehead Institute is the possibility of making paradigm-shifting discoveries that can lead to major advances in medicine.
Artificial intelligence (AI) is part of everyday life and has innumerable uses — from summarizing a book or designing a poster, to recommending a TV show or parking your car. But how can AI be useful in biology? In this video narrated by Whitehead Institute Member Richard Young, learn how scientists are taking advantage of AI to greatly accelerate biological discoveries.
The Whitehead Innovation Initiative, funded through a generous gift by Michael and Victoria Chambers, explores the power of AI tools in biological research, while establishing Whitehead Institute as a leader in applying AI tools to biological questions — often with direct implications for human health. Here are some of the achievements from the program's first year.
Whitehead Institute's Innovation Centers are a source of research services and much more, including potent collaborators and thought-partners. Graduate student Pushkal Sharma in Whitehead Institute Member Ankur Jain’s lab learned this firsthand by working with Heather Keys, the director of the Functional Genomics Platform, on research into small molecules called polyamines.

A parasitic vacuole with multiple parasites that have labeled parasitic Tubulin in yellow, parasitic and host DNA in blue, and parasitic Centrin in magenta, which highlights the parasite's centrosomes. The parasites have a knocked out gene that maintains chromatin in a poised state for rapid activation throughout the cell cycle and developmental transitions, so some of these parasites have aberrant centrosome formation. From https://www.biorxiv.org/content/10.1101/2025.07.16.665172v1.
Dominic Schwarz/Whitehead Institute
Whitehead Institute researchers are uncovering answers to some of biology’s most compelling mysteries: how tumors arise and progress; what allows certain animals to regenerate lost tissues; why COVID-19 can trigger vascular complications; and how temperature intersects with aging. These stories highlight some of this year’s discoveries and the ways they may inform advances in medicine and related fields.

Whitehead Institute's interdisciplinary approach to science brings together biologists with diverse expertise, computational and AI experts, physician-scientists, and others. They share ideas and collaborate across fields, driving breakthroughs for complex biological problems that no single perspective can solve. Our researchers also share their love of science with teachers and students through our public programs. Through this culture of collaboration and mentorship, Whitehead Institute is moving science forward and training the next generation of scientific leaders.

Whitehead Institute remembers David Baltimore: its Founding Director and a globally revered scientific leader
We fondly remember Nobel Laureate David Baltimore, who died September 6th. A brilliant scientist, with discovery after discovery Baltimore brought to light key features of biology with direct implications for human health. In 1982, Baltimore partnered with philanthropist Edwin C. “Jack” Whitehead to conceive and launch Whitehead Institute and then served as its Founding Director until 1990. Within a decade of its founding, the Baltimore-led Whitehead Institute was named the world’s top research institution in molecular biology and genetics.
“More than 40 years later, Whitehead Institute is thriving, still guided by the strategic vision that David Baltimore and Jack Whitehead articulated,” says former Board Member and fellow Nobel Laureate Phillip Sharp. “Of all David’s myriad and significant contributions to science, his role in building the first independent biomedical research institute associated with MIT and guiding it to extraordinary success may well prove to have had the broadest and longest-term impact.” In 2023, Whitehead Institute established the endowed David Baltimore Chair in Biomedical Research, honoring Baltimore’s six decades of scientific, academic, and policy leadership and his impact on advancing innovative basic biomedical research.
Baltimore (center) with the Founding Members (from left to right: Weinberg, Lodish, Jaenisch, and Fink) at a recent Whitehead Institute event celebrating the career of Gerry Fink.
Whitehead Institute
Baltimore (second from right) and his wife, Alice Huang, chatting with George Daley (left), dean of Harvard Medical School and a former graduate student in the Baltimore lab, and Harvey Lodish (right) at a recent Whitehead Institute event.
Whitehead Institute
Ruth Lehmann, director and president of Whitehead Institute, says, “I, like many others, owe my career to David Baltimore. He recruited me to Whitehead Institute and MIT in 1988 as a faculty member, taking a risk on an unproven, freshly-minted Ph.D. graduate from Germany. As director, David was incredibly skilled at bringing together talented scientists at different stages of their careers and facilitating their collaboration so that the whole would be greater than the sum of its parts. This approach remains a core strength of Whitehead Institute.”
Click here to read the rest of our remembrance of David Baltimore.

Descendants of progenitor cells in the lung (yellow) are visualized near the end of lung development, in conjunction with other cell type markers, including smooth muscle (cyan) and blood vessels (magenta).
Miram Meziane/Whitehead Institute
Trainees explain their science
Whitehead Institute’s trainees — its postdoctoral researchers and graduate students — are integral to the Institute's mission. Though early in their careers, these researchers ask bold questions and, through hard work and ingenuity, discover answers that deepen scientific understanding and often provide insights relevant to health and disease. With the work they do here and after they leave the Institute, they will maintain the vitality of the scientific enterprise for decades to come. Watch a few of our trainees explain their science in their own words in two of our video series: Science in 60, in which researchers explain their research in one minute, and Ask a Scientist, in which researchers answer questions from middle and high school students.
Xochitl Luna discusses investigating the role of microglia — the brain’s resident immune cells — in multiple sclerosis.
Henry Kilgore answers a 9th grader's question: How do proteins know where to go inside a cell?
Gayathri Muthukumar discusses how the outer mitochondrial membrane, which is a hub for signaling proteins, helps regulate mitochondrial functions.

Students observe planarians, flatworms known to regenerate, under a microscope.
Amy Tremblay/Whitehead Institute
Highlights from Expedition:Bio, Whitehead Institute's summer science program for middle school students
Whitehead Institute is committed to training the next generation of scientific leaders. In addition to our graduate students, postdoctoral researchers, and Whitehead Fellows, this commitment extends to the middle school and high school students that participate in our education and outreach programs, as well as the high school teachers enrolled in our high school teacher program. The programs provide potentially transformative experiences, exposing students, many for the first time, to the excitement of scientific research and new career possibilities.
Every summer, a group of rising seventh and eighth graders participate in Expedition:Bio — two weeks of engrossing hands-on science at Whitehead Institute, with an extra helping of fun. For a glimpse into their experience, we spoke to several students who joined this year's program, to hear about what they learned.
From constructing paper microscopes, to extracting DNA from strawberries and observing cells under a microscope — students encountered a wide range of activities and introductory concepts in biology. "It's fun, it's really interactive," Jacob Carvalho says. "We got to see the labs at Whitehead Institute."

Students learned pipetting and created beautiful artwork along the way.
Erica Stoloff/Whitehead Institute
Building the paper microscopes, called Foldscopes, was a standout activity among students. A Foldscope starts out as a flat sheet of paper, which a student bends and creases like origami, before adding a lens that magnifies samples up to 140 times. "I didn't think they would work. But we added our samples, and we could see something microscopic," Phoebe Cochis says.
Another highlight has been visiting the BioBuilder Learning Lab in Boston, where students used PCR, the laboratory technique used to detect and analyze particular DNA sequences in samples. The day's study subject was vitamin A-infused yeast, dubbed "golden yeast." This engineered yeast grows in a variety of colors — from deep reds to pale yellows and white — depending on its ability to synthesize the pigment beta-carotene. "We actually worked on the yeast," Carvalho says. "We got to incubate it, then saw the results the next day. There was orange, purple … each group had different colored yeast."
"The instructors are really good at explaining things to you. We got to see the results of our experiments," says Cochis, who appreciated not simply following instructions, but learning how things worked along the way. A handful of undergraduates, graduate students and postdocs graciously shared their time with Expedition:Bio — they ran workshops, gave tours of their workspaces, and answered questions about what it's like being a scientist. Sung Hwa Chang and Erica Stoloff, both high school teachers in the area, served as instructors over the two weeks, guiding students through each day's activities.
Most but not all learning happened inside a lab. Taking advantage of the warm summer weather, Expedition:Bio ventured to Mass Audubon's Drumlin Farm in Lincoln, Massachusetts. Students observed local flora and fauna — from water stick-bugs, to green frogs and their tadpoles. "Drumlin farm was really cool, because we actually got to go out in the field," Cochis says. "We were able to observe animals — not just observe them, but think of them in a more scientific way."

Observing the local flora and fauna at Mass Audubon's Drumlin Farm.
Erica Stoloff/Whitehead Institute
At Mount Auburn Cemetery in Watertown, science illustrator Sandy McDermott led a birding excursion, where students had the chance to observe a red-tail hawk and sketch it in their nature journals. Students also received an introduction to citizen science projects at Mount Auburn, including one focused on identifying mushrooms and another that monitors insect populations in relation to climate change.
The majority of participants in Expedition:Bio were newcomers, with some exceptions. "It's my second year here, I came back, so that's how much I liked it," Carvalho says. Aya Behhite, who worked as an assistant this year, was once an Expedition:Bio student herself. "It was definitely a lot of déjà vu. We would go somewhere, and I'd be like 'oh my gosh,' I remembered when I was here as a student." Behhite, who begins her sophomore year of high school, is thinking about studying biology in college, with her sights set on becoming a doctor or a researcher.
"My favorite moment is when the kids see something new, or they're doing an experiment. They see the results and they get really excited," Behhite says.
On the last day, students select a favorite activity from the past two weeks, and craft their own poster on the subject. Gathering in Whitehead Institute's cafeteria, the students present their findings to those attending. "It's so exciting to see kids who hadn’t considered pursuing science become interested in doing so after attending our programs," says Amy Tremblay, Whitehead Institute's Manager of Public Programs.
One of the main takeaways from these two weeks? Cochis sums it up: "There's a lot you're capable of, and there's a lot that you're able to learn, even if you're young. It just matters that you have a good teacher and you're motivated to do it."
Below are updates on inspiring core programs we offered in 2025, plus links to additional information on each.

After two weeks packed with science and fun, students created and presented posters on their favorite activity.
Erica Stoloff/Whitehead Institute
The Spring Lecture Series for High School Students encourages participants to explore the facts behind the science headlines and experience cutting-edge biomedical research. The three-day program, held over spring break, features lectures from leading scientific experts, hands-on...
Read moreA two-week summer exploration of the extraordinary variety of life around us, Expedition: Bio gives rising seventh and eighth grade students a fun, hands-on scientific immersion. Guided by expert instructors with more than 30 years of public school teaching and curriculum-building...
Read moreThe Seminar Series for High School Teachers offers educators the opportunity to explore topics at the forefront of biomedical research. Built around monthly science seminars that explore important challenges and introduce new tools and research findings, the program...
Read moreBioNook is Whitehead Institute’s online resource for K-12 science education. Launched during the height of the COVID-19 pandemic to offer students — and parents — a virtual and engaging way to learn about science, it continues to blossom. BioNook delivers a wealth of free...
Read more
HeLa cells being screened for various cellular components. A different gene has been silenced in each cell. This optical pooled screening method enables researchers to observe a vastly larger number of cells simultaneously, with precise knowledge of which gene is knocked out in each case. Using computational analysis, they can then infer how the absence of a specific gene alters the cell’s morphology.
Kuan-Chung Su; Matteo Di Bernardo; Kaitlyn Manzer/Whitehead Institute
Whitehead Institute celebrates the legacy of Founding Member and Former Director Gerald Fink
Whitehead Institute celebrated the legacy of its Founding Member and Former Director Gerald Fink at a retirement symposium held on May 13.
Fink is known for his pioneering work in yeast genetics — discovering how to “transform” yeast, introducing and propagating foreign DNA into the organism, developing it as a genetic model system — which has also led to important advances in the production of pharmaceuticals. Beyond his own research, he mentored scientists whose discoveries have reshaped a range of scientific fields.
Click here to read more about the celebration.
Fink's book, The Creation of Whitehead Institute: A radical experiment, published this year, is available for purchase from the MIT Press bookstore.
AI: Advancing Foundational Biology symposium highlights how AI is accelerating biomedical discovery
Artificial intelligence (AI) is reshaping how scientists are interrogating biological processes and drawing insights from the expansive datasets emerging from biomedical research. By uncovering hidden patterns and predicting experimental outcomes — among other applications — AI holds the potential to accelerate biomedical discovery.
This was the theme at AI: Advancing Foundational Biology, a symposium held at Whitehead Institute on April 8. The event featured talks by computational biologists and AI experts from Cambridge, New York, and Toronto, and drew an audience of over 400 researchers and students interested in exploring the intersection of AI and biology.
Click here to read more about the event.

Courtesy of Ron Vale
Whitehead Institute welcomes Ron Vale as its newest Member
Ron Vale, a world-renowned cell biologist who is an expert on motor proteins and cell transport systems, joins Whitehead Institute this December as a Member. In addition to this appointment, Vale is a Howard Hughes Medical Institute (HHMI) Investigator and will join the MIT Department of Biology faculty.
"It's very clear that Whitehead Institute contains a group of scientists who are deeply interested in one another's research, who form a close-knit and collaborative community, one with a strong training ethos," Vale says. "I think those qualities make for a wonderful place to work, and an amazing environment to do great science."

Courtesy of Maren Winnick
In conversation with biopharma investment leader Maren Winnick
When Maren Winnick joined the Whitehead Institute Board of Directors this year, she brought to the role deep expertise in finance and a keen understanding of how healthcare organizations navigate growth and communicate their impact to the world.
A senior managing director and partner at the global investment banking advisory firm Evercore, Winnick has guided major acquisitions by Novartis, Sanofi, and other leading biopharma companies. She also co-leads the Evercore Women’s Network, a community dedicated to supporting and mentoring women as they advance their careers in finance.
Click here to read a conversation in which Winnick shares why she chose to engage with Whitehead Institute and how she hopes to help guide its path forward.

The science done at Whitehead Institute lays the groundwork for technological innovations and medical advances that can impact people around the world. Whitehead Institute is building collaborative relationships with partners such as Boston Children's Hospital to speed up the pipeline from research result to real world effect. Whitehead Institute alumni carry on this mission through work in academic research, biotech, medicine, and other fields.

Courtesy of Terry McGuire
Laying foundations for the future
As a venture capital leader, Terrance (Terry) McGuire has spent his career advancing breakthroughs in medicine and information technology. Recognized as one of Forbes’ Top Life Sciences Investors and included in Scientific American’s Worldview 100, he has long been committed to turning transformative ideas into real-world solutions.
In 2022, McGuire joined the Whitehead Institute Board of Directors. And this year, through the McGuire Family Foundation, he and his wife, Carolyn Carr McGuire, made a $100,000 gift to support Whitehead Valhalla Fellow Aditya Raguram’s lab.
Raguram and his team are developing novel methods to deliver large genome-editing proteins into cells — an approach that could power the next-generation of therapies capable of silencing or correcting disease-causing genes. We sat down with Terry to learn more about what inspired the family’s support.
Click here to read the full interview.

An immunofluorescence image of an ovary that expresses a tool designed for degrading proteins of interest in the egg. Here it appears to be toxic: the ovary did not develop properly.
Marty Alani/Whitehead Institute

Clockwise from top left: Ann Boija, Whitney Henry, Isaac Klein, Diego Huet, Shawn Liu, Boryana Petrova
Courtesy of Ann Boija, Whitney Henry, Isaac Klein, Diego Huet, Shawn Liu, Boryana Petrova
Meet Whitehead Institute Alumni
Whitehead Institute is committed to training the next generation of scientists to be innovative, curious, courageous thinkers who will pursue work that has the potential to make a meaningful impact on science and society. Every year, Whitehead Institute labs welcome new postdoctoral researchers, and say goodbye to postdocs who have completed their work here and are moving on to the next stage in their careers. Six Whitehead Institute alumni who were originally featured in our "Meet a Whitehead postdoc series" have returned for a new Q&A to reflect on how their time at Whitehead Institute informed their careers and share updates on where they are now. Read more.

Researchers and clinicians from Whitehead Institute, MIT, and Boston Children's Hospital chat during the event.
Whitehead Institute builds scientific bridges to advance human health
Since its inception, Whitehead Institute has driven groundbreaking discoveries in the basic biology of health and disease while training the next generation of biomedical innovators. This past year, its mission of improving human health through foundational research gained new momentum when Whitehead Institute convened physicians and scientists at Boston Children’s Hospital with Whitehead Institute and Massachusetts Institute of Technology researchers, uniting the vibrant research ecosystems on either side of the Charles River. Read more.

Gretchen Ertl/Whitehead Institute
A look inside the Whitehead Fellows Program
Since its founding by David Baltimore in 1984, the Whitehead Fellows Program has served as a launchpad for exceptional early-career scientists, many of whom will go on to become leaders in academia, research, and the biotechnology industry. In doing so, the program has advanced Whitehead Institute’s mission forging new frontiers in science, uncovering insights today that unlock the potential of tomorrow.
Discoveries from the Fellows’ labs have yielded profound insights across a range of scientific topics, including the genetic drivers of drug addiction, the gene regulatory role of sex chromosomes, strategies to rally the immune system against cancer, and exposing vulnerabilities in some of the most treatment-resistant cancers.
As a result of the group’s collective achievements, the Fellows Program has established an enduring legacy. The Program’s alumni include current and former heads of major research centers, leaders of extraordinarily productive laboratories at many of the nation’s most respected universities, a White House science advisor, a NASA astronaut, a dean of Harvard Medical School, senior executives at major biomedical companies, and four current Members of Whitehead Institute. Their exceptional contributions have been recognized with some of the field’s highest honors, including the MacArthur Fellowship, the Breakthrough Prize, HHMI Investigator appointments, and election to the National Academy of Sciences.
Beyond their scientific achievements, Fellows are dedicated mentors and educators, training undergraduates and graduate students, supporting early-career researchers, and contributing meaningfully to the broader Whitehead Institute community.
To further build on its tradition of empowering emerging scientific talent, Whitehead Institute recently established the AI Fellowship, which enables recent PhDs or MDs to launch independent research groups focused on applying artificial intelligence to fundamental biological research. The expertise of Whitehead Institute’s inaugural AI Fellow, Na Sun, will be a valuable resource for Whitehead Institute researchers seeking to employ AI and other deep learning techniques to answer fundamental biological questions.
Curent Whitehead Fellows include: Na Sun and Whitehead Valhalla Fellows Lindsey Backman, Tobiloba Oni, Allison Hamilos, and Aditya Raguram. Valhalla Fellow Kipp Weiskopf completed his tenure this fall. Read more about their research in the “Our Science” section above.

A study of nucleolar processes and rRNA synthesis. Nuclei in cyan, and nucleoli components: fibrillar center in green and nacent rRNA in red.
Giuseppe Dall'Agnese/Whitehead Institute

Sarah Williamson
Courtesy of Sarah Williamson
A year of change and renewal
Whitehead Institute empowers the best scientists to ask bold, fundamental questions in biology. While this research is not always predictable, it is the driving force behind medical innovation and clinical progress.
Our researchers include physician-scientists studying childhood leukemias, lymphomas, brain cancers, and fatty liver disease, among other conditions. By combining clinical insights with foundational research, they are seeking breakthroughs that transform patient outcomes.
What draws them to Whitehead Institute is our collaborative environment, where experts from diverse fields work together to tackle biological problems that have remained unsolved for decades. This interdisciplinary approach is exactly how transformative therapies are made possible.
This has been a year of change and renewal for Whitehead Institute, even as the landscape of biomedical research funding shifts. We’ve welcomed new scientists and launched ambitious research directions, while navigating moments of loss.
The passing of our Founding Director, David Baltimore, has caused us to reflect on the bold vision on which this Institute was built: to support brilliant minds in pursuing foundational research that expands our understanding of biological processes and, in doing so, advances human health. We are thrilled to welcome Ron Vale to our community and to see researchers at every stage of their careers pursuing ideas that lay the groundwork for tomorrow’s therapies and technologies.
Efforts like the Whitehead Innovation Initiative, which advances the use of artificial intelligence in biology, further our mission by helping us explore biological problems with unprecedented depth and scope. But the journey from an initial question to a transformative therapy is rarely straightforward. Breakthroughs take years, sometimes decades, to realize. This is why sustained investment in foundational science is so critical.
At a time when, as a country, we are reconsidering the enterprise of science, we thank you for your belief in the power of foundational science. Forging new frontiers in science, uncovering insights today that unlock the potential of tomorrow, is what defines Whitehead Institute. Thank you for joining us in this mission.

Sarah Keohane Williamson
Chair, Board of Directors

Fly embryos at various stages of development. Using balancer chromosomes expressing fluorescent markers, the researchers can distinguish between embryos that have two mutant copies of a gene and those that have wild-type genes. This allows them to determine which stages of embryogenesis are disrupted when the gene of interest is mutated. Green is GFP staining against cytoplasmic GFP expressed from balancer chromosomes. Red is ATP5a staining for mitochondria. Blue is DAPI staining for DNA.
Melissa Pamula/Whitehead Institute
Awards and recognitions
Below is a sampling of the honors and major grants received by Whitehead Institute researchers this past year.

Election to the Academy is one of the most prestigious honors a scientist can receive; it recognizes demonstrated excellence and achievement in science. Yamashita was recognized for her groundbreaking work on how germline cells, which become eggs or sperm, are able to pass on genes from one...
Read more
Awarded by Gladstone Institutes, the prize recognizes Jaenisch's seminal role in establishing and advancing the field of induced pluripotent stem cells (iPSCs), adult skin or blood cells that can be reprogrammed into an embryonic stem cell–like state. These reprogrammed cells can...
Read more
Lourido received this award — Tulane University's highest honor for alumni — in recognition of an individual who "epitomizes the potential of a Tulane education and thereby brings credit and honor to the School and University." Lourido's lab investigates how the ubiquitous single-cell...
Read more
Ly, who is advised by Whitehead Institute Member Iain Cheeseman, was one of six laureates selected by The Max Birnstiel Foundation and the Research Institute of Molecular Pathology (IMP) this year. The prestigious international award recognizes Ly's work on largely unstudied protein...
Read more
Ly was additionally awarded the Porter Prize for Research Excellence by the ASCB. The prize places emphasis on "contributions to the advancement of science and the novelty and creativity of their findings." Ly is one of 15 researchers selected for the 2025 cohort.

The Gilliam Fellowship supports graduate students and their advisors through funding, leadership training, and plentiful mentorship opportunities. Jefferson, who is co-advised by Whitehead Fellow Tobiloba Oni and MIT Biology Professor and Koch Institute Founding Director Tyler Jacks,...
Read moreDirector and editor: Lisa Girard
Assistant editor: Greta Friar
Writers: Greta Friar, Merrill Meadow, Amy Tremblay, Madeleine Turner, Shafaq Zia
Cover image: Melissa Pamula
Primary photography: Gretchen Ertl
Additional photography: Amy Tremblay, Madeleine Turner, Erica Stoloff, Shafaq Zia
Photography also provided courtesy of: Ann Boija, Whitney Henry, Diego Huet, Isaac Klein, Shawn Liu, Jimmy Ly, Terry McGuire, Boryana Petrova, Sarah Williamson, Ron Vale, Maren Winnick
Section banners: Jennifer Cook-Chrysos
Special Features cover image: Han Tran
Scientific images: Marty Alani, Giuseppe Dall'Agnese, Miram Meziane, Melissa Pamela, Dominic Schwarz, Kuan-Chung Su and Matteo Di Bernardo and Kaitlyn Manzer
Digital design: WDB Agency, additional design work by Subbiah Design



















